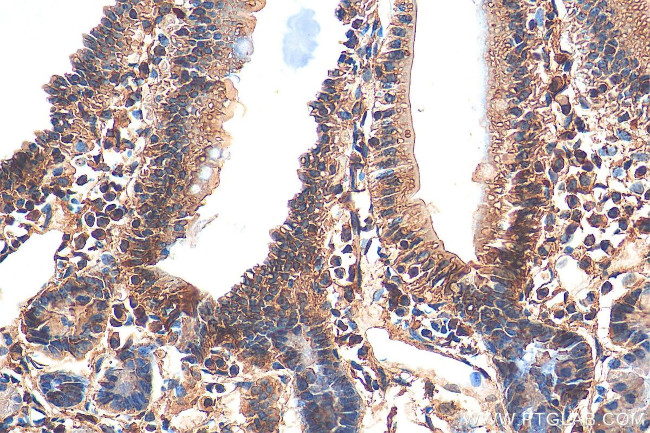
AHR Antibody in Immunohistochemistry (Paraffin) (IHC (P))

Search
Proteintech
AHR Polyclonal Antibody
{{$productOrderCtrl.translations['antibody.pdp.commerceCard.promotion.promotions']}}
{{$productOrderCtrl.translations['antibody.pdp.commerceCard.promotion.viewpromo']}}
{{$productOrderCtrl.translations['antibody.pdp.commerceCard.promotion.promocode']}}: {{promo.promoCode}} {{promo.promoTitle}} {{promo.promoDescription}}. {{$productOrderCtrl.translations['antibody.pdp.commerceCard.promotion.learnmore']}}
产品信息
28727-1-AP150UL
种属反应
宿主/亚型
分类
类型
偶联物
形式
浓度
规格
纯化类型
保存液
内含物
保存条件
运输条件
靶标信息
AHR (Ah Receptor) belongs to a family of proteins comprised of its dimerization partner ARNT (HIF-1 Beta) and the Drosophila proteins PER and SIM. AHR contains an N-terminal sequence of approximately 200 amino acids termed the PAS domain. AHR, found in a variety of tissues, binds to a specific DNA enhancer sequence and initiates transcription of the mRNA for the cytochrome P-450 (CYPIA1) gene. The gene for AHR encodes a ligand-activated transcription factor involved in the regulation of biological responses to planar aromatic hydrocarbons. AHR has been shown to regulate xenobiotic-metabolizing enzymes such as cytochrome P450, and its ligands included a variety of aromatic hydrocarbons. AHR is a ligand-activated helix/loop/helix transcription factor found in a variety of vertebrate species. The known ligands for AHR are foreign planar aromatic compounds, such as polycyclic aromatic compounds and halogenated aromatic compounds such as 2,3,7,8-tetrachlorodibenzo-p-dioxin (TCDD). Unlike the steroid/thyroid hormone receptors, there is no known physiological ligand for AHR. Studies indicate that in non-ligand activated cells, AHR is found complexed with HSP90 predominantly in the cytoplasm. Upon binding to an agonist, the ligand-activated AhR is believed to transform to a nuclear, DNA binding form, and this transformation process appears to involve dissociation of HSP90 from AhR followed by formation of a heterodimer with AhR nuclear translocator protein (Arnt). Diseases associated with AHR include eosinophilic fasciitis and seborrheic dermatitis.
仅用于科研。不用于诊断过程。未经明确授权不得转售。
篇参考文献 (0)
生物信息学
蛋白别名: Ah receptor; AH-receptor; aromatic hydrocarbon receptor; Aryl hydrocarbon receptor; bHLHe76; Class E basic helix-loop-helix protein 76; dioxin receptor
基因别名: Ah; Ahh; AHR; Ahre; BHLHE76; FVH3; In; RP85
UniProt ID: (Human) P35869, (Mouse) P30561
Entrez Gene ID: (Human) 196, (Mouse) 11622